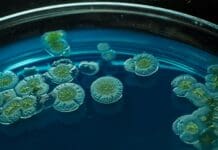
Bugs for Better Health: A Biological Route to Gout Prevention
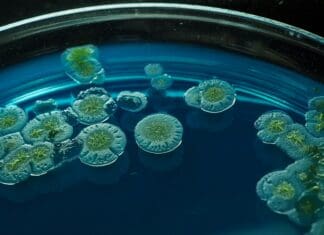
Bugs for Better Health: A Biological Route to Gout Prevention

This post is also available in:
עברית (Hebrew)
By ARIE EGOZI
The technologies involved in the development of new weapon systems are so complicated that the manufacturers use them “across the board” for different systems.
Israeli defence contractors have used this approach for some years and all signs point to a growing trend.
Some of these technologies transferred from one weapon system to another are classified but one good example can prove the trend.
Rafael in Israel has developed some very advanced air-air missiles. But if you want to see some future designs, that will be impossible. That is not because of secrecy considerations, but because the effort has been shifted some years ago to other missiles.
The need of armed forces to defend themselves on the move, has brought Rafael to use two of its combat proven air-air missiles, the Python-5 and the Derby, to offer clients a mobile point defense system based on these two missiles, this time in a surface – air role.
That was the turning point that led to the development of “building blocks” that can be used at any given time for the development of air – air missiles.
So if you want to see how the next generations of Israeli developed air-air missiles will look like and perform, turn your eyes to some missiles that are being developed now for other tasks. One good example is the “Stunner” that is being developed by Rafael and Raytheon as part of another system, the “David’s Sling”. This system is aimed at intercepting longer range rockets. Details are classified but this is the stuff future air-air missiles will be made of.
So to know the shape of air -air missiles to come, at least those made in Israel, look at the missiles that are being used for less exotic missions. These are the building blocks. The offspring will look very similar.